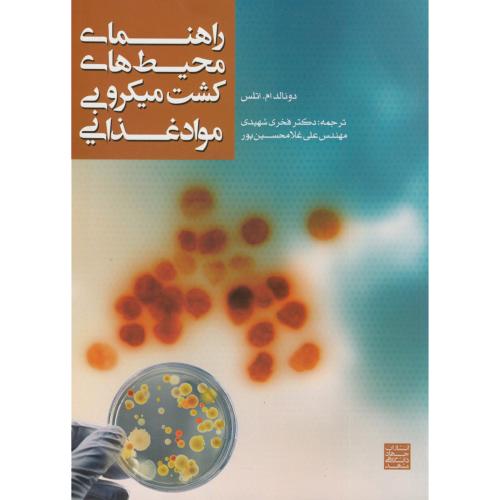

خرید و دانلود نسخه کامل کتاب The Practice of Electroconvulsive Therapy: Recommendations for Treatment, Training, and Privileging PDF

الی فایل
خرید و دانلود نسخه کامل کتاب The Practice of Electroconvulsive Therapy: Recommendations for Treatment, Training, and Privileging PDF
گزارش
محصولات مشابه

کتاب راهنمای آرایش و مراقبت از پوست
86,250 تومان

تشریح کامل مسائل مبانی الکترونیک جلد دوم چاپ 1-87
80,000 تومان

کتاب تحولات خدمات روانپزشکی در ایران تلاشی چهار ساله 1353 1357
93,500 تومان

کتاب کنترل متابولیسم
80,100 تومان

کتاب اطلس رنگی اتاق خواب
95,000 تومان

تست مامان (چگونه با مشتریان صحبت کنید و درحالی که به شما دروغ می گویند) - کتابفروشی کوچه کتاب
93,750 تومان

دانلود جزوه تکنولوژی روغن های خوراکی دانشگاه علوم پزشکی شهید بهشتی
79,000 تومان

واستو (کتاب کوچک معماری ودایی)
90,000 تومان

گیاه خواری رژیم های غذایی و مکمل ها
79,000 تومان

گیاه درمانی شناخت و درمان بیماریها
89,000 تومان

مبحث 22 بیست و دوم مقررات ملی ساختمان مراقبت نگهداری از ساختمان ها 1392 - فروشگاه کتاب اشراق
93,000 تومان

قیمت و خرید کتاب نگرشی بر زمین شناسی و اکتشافات منابع | ایده بوک
95,000 تومان

کتاب شاهکارهای معماری خانه های شهری جهان ( آپارتمان-مجتمع ها )
85,000 تومان

چند کلمه حرف حساب درباره ی بدن
79,000 تومان
کتاب زلزله شناسی مهندسی و شبیه سازی زمین لرزه
90,160 تومان

خرید و دانلود نسخه کامل کتاب Semigroups of Linear Operators: With Applications to Analysis, Probability and Physics
79,500 تومان
کتاب راهنمای محیط های کشت میکروبی مواد غذایی
84,550 تومان

کتاب ماده تاریک و انرژی تاریک
90,000 تومان

دانلود نسخه کامل کتاب آموزش کندل شناسی فوق العاده کامل شمعی ژاپنی
89,000 تومان

آشنایی با : زبان اسمبلی و معماری ریزپردازنده 80x 86 ( ریچارد سی دتمر – هاشم مشحون )
80,000 تومان
بررسی تغییرات قیمت
خرید و دانلود نسخه کامل کتاب The Practice of Electroconvulsive Therapy: Recommendations for Treatment, Training, and Privileging PDF
Hello, world! This is a toast message.